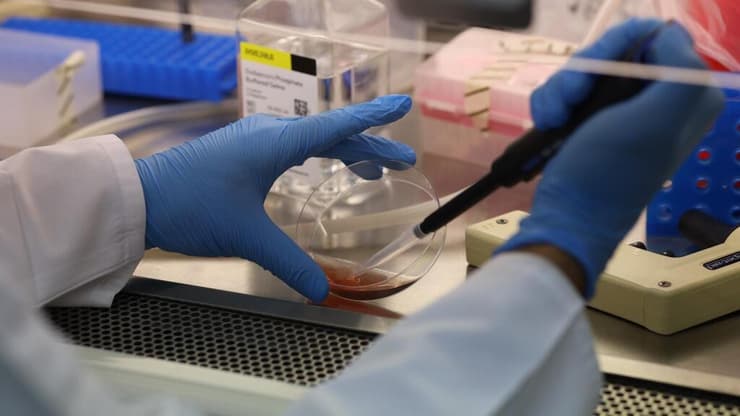
מעבדת בנק הדם בקריה הרפואית רמב"ם

מצוקת הדם בישראל גוברת על רקע המלחמה עם איראן – והבקשה לתרומות דם מתמקדת הפעם לא רק בכמות, אלא גם בסוג: O. זהו סוג הדם המבוקש ביותר במערכת הבריאות, כזה שיכול להציל חיים גם כשזהותו של המטופל עדיין לא ידועה. למרות יתרונו האוניברסלי – המלאי מתרוקן מהר, והמערכת מתריעה: אנחנו מתקרבים לקצה.
ישנם ארבעה סוגי דם הנקבעים לכל אדם באופן גנטי עם לידתו: O, B, A ו-AB. כל סוג מתחלק לשני תתי-סוגים – חיובי ושלילי – בהתאם לקיומו של גורם Rh על פני כדוריות הדם.
5 צפייה בגלריה


סוג דם O הוא סוג אוניברסלי, כלומר – מתאים לכולם. בתמונה: התרמת דם באיכילוב
(צילום: עידו ארז)
"מי שיש לו סוג דם חיובי יכול לקבל גם שלילי, אבל מי שיש לו סוג דם שלילי חייב לקבל שלילי בלבד", מסבירה ד"ר אינה צורן, מנהלת האשפוז ההמטולוגי בקריה הרפואית רמב"ם. "זה חשוב במיוחד אצל נשים בגיל הפוריות, ילדות ונשים בהיריון – כדי למנוע סיבוכים אפשריים בעתיד".
מה הופך את סוג דם O לחשוב כל כך במערכת הדם?
"סוג דם O הוא סוג אוניברסלי, כלומר – מתאים לכולם", מסביר ד"ר רפאל סטרוגו, סמנכ"ל רפואה ושירותי הדם של מד"א. "בסוג דם זה אין אנטיגנים על הכדורית ולכן אם אני אתן סוג דם O למטופל בעל סוג דם A, הנוגדנים שיש לו בדם לא יתקפו את הכדורית".
מה יש במנות הדם? כל מה שצריך לדעת
ד"ר צורן מוסיפה: "סוג דם זה ניתן לכל מי שנזקק למנת דם – עוד לפני שאנחנו יודעים מה סוג הדם שלו. במקרים של טראומה, הרבה פעמים בדקות הראשונות, לפני שיש סיווג, נותנים סוג דם O. גם חולים שמקבלים מוצרי דם ביום-יום – כמו מושתלים או חולי סרטן שעוברים השתלת מח עצם מתורם – מקבלים בדרך כלל סוג דם O, מה שהופך את הביקוש אליו לעוד יותר גבוה".
לא נדיר, אבל מתרוקן מהר
כ-30% מהאוכלוסייה הם בעלי סוג דם O, כך שהוא אינו נדיר – אך דווקא משום שכל כך הרבה אנשים נזקקים לו, מדובר במלאי הראשון שמתרוקן, בעיקר בתקופות חירום שבהן נדרשות כמויות גדולות של מוצרי דם.
ד"ר אינה צורןצילום: הקריה הרפואית רמב"ם"בדרך כלל כשמישהו תורם דם, מפרקים את המנה למרכיבים – כדוריות אדומות, טסיות (תאים בעלי תפקיד מרכזי בקרישת דם), ופלזמה קפואה – וכל מטופל מקבל רק את מה שהוא זקוק לו", מסבירה ד"ר צורן. "אבל כיום, במיוחד במצבים של פציעה קשה, נותנים כבר בשטח מנת דם מלאה מסוג O מבלי לפרק אותה, ולכן עוד יותר חשוב שיהיה לנו מלאי גדול דווקא מהסוג הזה".

לדברי ד"ר צורן, למרות המיקוד בסוג דם O, חשוב לזכור שכל סוגי הדם דרושים – כולל הסוגים הנדירים יותר. "סוג דם AB, למשל, הוא הכי נדיר, וממנו מפיקים את הפלזמה הקפואה האוניברסלית – כי אין בו נוגדנים נגד סוגי דם אחרים", היא מסבירה. "יש אנשים שמפתחים נוגדנים לתתי-סוגים – במיוחד אם קיבלו מנת דם בעבר, או נשים שהיו בהיריון – ואז הם זקוקים למוצרי דם שתואמים להם בדיוק. לרוב האנשים אין מידע מה תת-הסוג שלהם, אלא אם כן תרמו דם בעבר ועברו אפיון ספציפי, ולכן מי שיודע שהוא AB – כדאי מאוד שיגיע לתרום".
ד"ר סטרוגו, סמנכ"ל רפואה ושירותי הדם של מד"א: "בתוך כל השגרה באים ה'פיקים' – למשל, אירוע של נפילת טילים או פיגוע עם עשרות פצועים מביא לפיק של התרמות, עם ישראל מגיע בהמוניו, אבל בשגרה הציבור מתעייף מהר. כדי לעמוד בצרכים השוטפים, אנחנו זקוקים ל-1,200 תורמים מדי יום – לפחות"
ד"ר לילך בונשטיין, מנהלת מעבדת בנק הדם בבית החולים רמב"ם, מדגישה: "אי אפשר לייצר דם במעבדה. זו רקמה שאפשר להעביר מאדם לאדם – אבל לא לייצר במעבדה. ולכן כל תרומה באמת מצילה חיים".
לדבריה, המחסור הנוכחי חמור במיוחד משום שהוגדר מצב של כוננות על ידי משרד הבריאות. "אנחנו צריכים להחזיק מלאי גדול יותר מהרגיל – וזה לא פשוט", היא אומרת. בימים הראשונים של הלחימה ירדה פעילות בתי החולים בעקבות ביטול זמני של טיפולים אמבולטוריים. עם זאת, ברמב"ם – שמפעיל בית חולים תת-קרקעי – חלה דווקא עלייה בפעילות, משום שחולים הועברו אליו ממוסדות אחרים. תודה לאל, עד עכשיו לא נאלצנו לבטל ניתוחים או טיפולים, אבל כשיש מחסור בדם, זה מה שקורה".
ד"ר לילך בונשטייןצילום: הקריה הרפואית רמב"םגם ד"ר צורן מתייחסת להשפעה האפשרית על ניתוחים מתוכננים: "במקרים כאלה, ניתוחים אלקטיביים עלולים להידחות – עד שמובטח שיהיו כל מוצרי הדם שהמטופל זקוק להם". לדבריה, במצב חירום, נדרש מלאי גדול פי ארבעה וחצי מהכמות הרגילה בשגרה – מה שמחייב גיוס מאסיבי של תרומות.
מה קורה במצבי קצה, כשהמלאי מידלדל והלחץ בשיאו?
במקרים אלו הצוותים נאלצים לפעמים לעבוד תחת אילוצים. "יש לנו דרגות חופש – לפעמים צריך להחליט מה יותר מסוכן: לא לתת כלום, או לתת משהו שהוא אולי פחות מתאים", מסבירה ד"ר בונשטיין. "אבל אנחנו מאוד לא רוצים להגיע למצבים האלה. במצבים אחרים מד"א מתבקשת לספק מוצרי דם נוספים, ובמקרים מסוימים נעשה גם שיתוף פעולה עם בתי חולים אחרים באזור. אלו מצבי קיצון שאנחנו מאוד משתדלים להימנע מהם – אבל הם בהחלט אפשריים כשאין מספיק תורמים".
"אין מספיק תורמים"
על רקע הנתונים, הקריאות וההיערכות – נותר המסר המרכזי: אין תחליף לתרומת דם, ואין זמן מתאים יותר לפעול מאשר עכשיו. "מה שצריך לקדם בכל הכתבה הזאת", אומרת ד"ר צורן, "זה פשוט שיבואו אנשים לתרום".
ד"ר בונשטיין מצטרפת: "כרגע הבעיה האמיתית היא לא התפעול – אלא ההיענות הציבורית. יש לנו את היכולת להכין, לשנע, ולתמוך – אבל אין מספיק תורמים. בדרך כלל, בזמן חירום, אנחנו רואים התגייסות של הציבור. זה שהפעם אין – זה מאוד עצוב. יש חולים שהמצב שלהם קשה, שזקוקים למנות דם כל הזמן – לא רק במלחמות ולא רק בפיגועים. אלה החולים ההמטולוגיים, ילדים ומבוגרים, שאינם מפסיקים להזדקק לטיפול – גם עכשיו".
ד"ר בונשטיין: "יש לנו בינה מלאכותית, טכנולוגיה שמביאה אותנו למאדים, מדפסות שמייצרות איברים – אבל דבר אחד עדיין אין לנו: דם מלאכותי. כשהאדם שמולך זקוק למנה שתציל את חייו – המקור היחיד הוא אדם אחר"
ד"ר צורן מזכירה כי לאחר 7 באוקטובר, התרומות זרמו. "היו תורים. אנשים הגיעו. והיום? למרות שאנחנו רואים חדשות על פצועים, יש פחות תגובה. חשוב לעורר את זה מחדש." וד"ר בונשטיין מסכמת באחת האמירות שנשמעות שוב ושוב בין כותלי בנק הדם: "יש לנו בינה מלאכותית, טכנולוגיה שמביאה אותנו למאדים, מדפסות שמייצרות איברים – אבל דבר אחד עדיין אין לנו: דם מלאכותי. כשהאדם שמולך זקוק למנה שתציל את חייו – המקור היחיד הוא אדם אחר. ואת זה אנשים חייבים להבין".
ד"ר רפאל סטרוגו, סמנכ"ל רפואה ושירותי הדם של מד"א, מבהיר כי נכון לעכשיו אין מחסור נקודתי במנות דם – אך הבעיה עמוקה יותר. "האתגר האמיתי שלנו הוא לא ברגעי חירום, אלא דווקא בשימור השגרה הנדרשת. מד"א אחראי 365 ימים בשנה לאיסוף, עיבוד, סיווג והפצה של מנות דם לכלל בתי החולים – בעיקר לטובת חולים, יולדות, ניתוחים, מושתלים. מצבי טראומה ואירועי חירום הם רק חלק קטן מהתמונה".
5 צפייה בגלריה


ד"ר סטרוגו: "האתגר האמיתי שלנו הוא לא ברגעי חירום, אלא דווקא בשימור השגרה הנדרשת"
(צילום: דוברות מד"א)
לדבריו, בעוד במצבים מהסוג הזה, כמו המלחמה עם איראן, הציבור נוהר לתרום דם – בשגרה, ההיענות דלה. "בתוך כל השגרה באים ה'פיקים' – למשל, אירוע של נפילת טילים או פיגוע עם עשרות פצועים מביאים לפיק של התרמות, עם ישראל מגיע בהמוניו, אבל בשגרה הציבור מתעייף מהר. אנחנו מפעילים מדי יום כ-30 אתרי התרמה בפריסה ארצית, עם מעל ל-100 צוותים. כדי לעמוד בצרכים השוטפים, אנחנו זקוקים ל-1,200 תורמים מדי יום – לפחות".
ד"ר צורן: "סוג דם O ניתן לכל מי שנזקק למנת דם – עוד לפני שאנחנו יודעים מה סוג הדם שלו. במקרים של טראומה, הרבה פעמים בדקות הראשונות, לפני שיש סיווג, נותנים סוג דם O. זה מה שהופך את הביקוש אליו לעוד יותר גבוה"
"היינו לא פעם על הקשקש"
האתגר מחריף במיוחד כאשר המדינה נכנסת למצב כוננות. "במעבר משגרה לחירום, כמו שקרה בשבוע האחרון, יש לנו רק ימים ספורים להעלות את רמות המלאי לרמה הנדרשת", אומר ד"ר סטרוגו. "זה בדיוק מה שהיה בשבוע האחרון: נכנסנו לאירוע החירום עם מלאי דם בעייתי לאחר ששלושה חודשים אנחנו צועקים 'בואו להתרים' והציבור מדשדש. היינו צריכים מהר-מהר להגיע למלאי הנדרש בתוך ארבעה ימים. למזלי, הצלחנו להגיע ליעד".
למרות ההתרעות, מד"א טרם הגיע לנקודת השבר – אך ד"ר סטרוגו לא מהסס להבהיר עד כמה המצב יכול להידרדר. "למזלנו, עד היום לא הגענו לשם, אבל אני יכול להגיד שבשנים האחרונות, בתקופות שונות של שגרה, היינו לא פעם על הקשקש. פרופ' שנער, קודמתי בתפקיד, ואני לא היינו ישנים בלילות – היינו במצב גבולי. אמנם לא הגענו למצב שיולדת מדממת ולא היה דם לתת לה, אבל אנחנו ממש מתקרבים לשם ואני לא רוצה לחשוב על זה".
אילו צעדים ננקטים במד"א כדי להתמודד עם המצב?
"כל יום אנחנו עושים תוכנית של התרמות בפריסה ארצית, במקומות ציבוריים", אומר ד"ר סטרוגו. "למשל, עד עכשיו פעלנו תחת מגבלות של פיקוד העורף בכל מה שקשור להתקהלויות – זו ממש הפעלה מבצעית. צריך לאתר את האתרים שעומדים בדרישות, להביא את הקהל בלוחות זמנים שלא תיווצר התקהלות, ולהתאים את הפעילות למצב. כל פעם אנחנו בונים תוכנית נקודתית לאותו יום – בהתאם למצב, בהתאם לאזורים – כדי לעמוד ביעד הנדרש".
האם יש לכם תוכניות מגירה למקרי קיצון – כמו מחסור כלל-ארצי?
"יש מערך חירום שלם שמד"א בנה לתרחישים כמו רעידת אדמה, לדוגמה. יש לנו הסכמים עם בנקי דם בעולם – עם גרמניה ועם ארצות הברית – ואפילו תרגלנו את זה כמה פעמים יחד עם רשות החירום הלאומית - תרחיש של יבוא מנות דם מבנקי דם באירופה ובארה"ב והטסה שלהן לארץ. זה קיים. אני לא יכול להגיד שזה אי פעם נעשה בסקייל של 'תביאו לי עשרת אלפים מנות', אבל כתבנו את התוכנית, תרגלנו אותה – והיא קיימת. ולמזלנו, עד היום לא היינו צריכים לממש אותה".